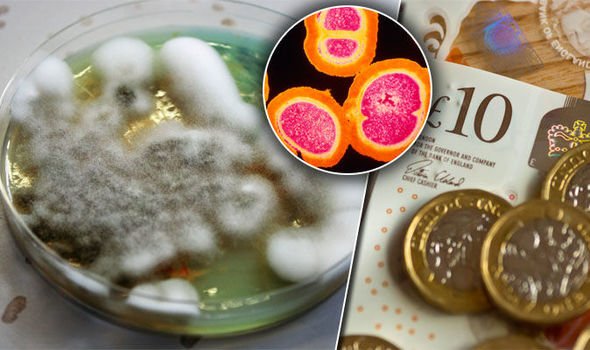

MRSA bacteria infection can lead to painful skin boils and food poisoning. But, the deadly superbug has been spotted on this common household item, along with a number of other types of bacteria, including listeria. It’s a “breeding ground� for killer superbugs, warn scientists.
[ad_2]
Read More